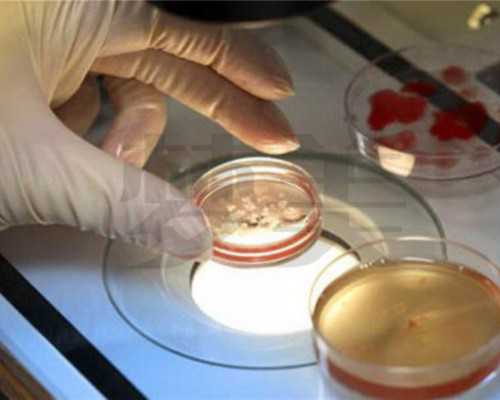
试管婴儿在家香港验血测男女吗_香港验血的宝妈说说_验血查男女哪个验机构准

试管婴儿在家香港验血测男女吗_香港验血的宝妈说说_验血查男女哪个验机构准
(香港验血检测胎儿性别的条件)(香港化验血液性别)(香港验血报告单男女显示)
香港验血的宝妈说说_验血查男女哪个验机构准!大家怀孕的时候肯定做检测最多的要属B超,但是有些东西虽说对自己的健康有好处,但是凡事都要有度才能达到更多的效果。那么B超做多了是不是真的不好呢。说到底,其实人类社会发展至今,每个人都有着很大的贡献。因为人类社会的发展和人类的延续有着不可断绝的联系,而人类的延续则是需要每一个人来共同承担这一使命。所以,很多夫妻在结婚以后都会选择生育自己的下一代。不仅是为了一个家庭,也是为了人类文明的延续。但是,关于下一代,我想很多夫妻都很重视下一代的性别,在宝妈刚怀孕,很多夫妻不禁猜测腹中胎儿的性别,到底是男是女呢?关于这个问题始终困扰着宝妈们。所以很多宝妈为了能够清楚胎儿的性别,都想要给胎儿做性别鉴定。
因为我们都知道,现今社会发达,科技兴盛,各种性别鉴定技术也是日新月异,关于宝宝的性别已经不是什么问题了。宝妈们想要尽早知道胎儿性别可以通过科学的检测技术来判别。而说到当下最为盛行的检测技术,那就非香港验血测男女了。因为这项检测有这科学,准确,快速等优势而盛行大陆。可是关于此,很多宝妈们还是会有所困惑:为什么发现怀孕不能马上去香港测男女?一定要等到7周呢?为了解决宝妈们的困扰,接下来我就来为大家普及一些香港验血知识。
所谓的香港验血检测也被称作七周验血检测,因为它是一种通过检测宝妈血液中胎儿的DNA进而进行检测的一项科学手段。其原理主要是通过采取女性的静脉血进行DNA化验,从而可以确定出胎儿的的DNA成分,判别出胎儿的性别。
因为我们都知道,胎儿在生长发育过程中,这段时间内,胎儿会有很多新老细胞进行交替,新的细胞产生,老化的细胞就脱落的,而这些脱落的细胞,会通过渗透进而进入到宝妈的血液循环系统中。所以检测人员通过抽取宝妈的血液就可以判断胎儿的DNA特性了。一般女性体内是不存在Y染色体的,所以可以通过检测宝妈体内是否存在Y染色体判断胎儿的性别。
我们都知道Y染色体是男性和女性性染色体的最主要区别。而性染色体又决定了宝宝的性别,所以检测过程中如果发现Y染色体,那么就一定是宝宝所含有的,因为宝妈原本体内并不存在,所以一旦检测到,就可确定宝宝是男性了。反之,检测不到,那么就是女孩儿。
关于Y染色体的检测方法主要是通过对其染色处理,因为此前已被证实,Y染色体上面含有一种被命名为"SRY"的基因,而这种基因又特定存在于Y染色体上,因此,这就为检测Y染色体的存在与否提供了方法。这种基因能够被特定的试剂染色,并且发生特殊的颜色变化,所以检测人员通过染色,进而观察其颜色变化,就可以确定宝妈血液中是否存在Y染色体了。而如果检测到Y染色体就可以确定宝宝为男性,如果没有,那么就为女性。
以上是关于香港验血检测原理的普及,那么记下来我们需要了解关于香港验血需要注意的相关事宜,这是极为关键的,务必各位宝妈牢记于心。
1、宝妈一定要等到孕期达到了7周或者以后才能进行检测,切不可心机,因为时机不到,检测不准确,只有等到孕期达到要求,并且在当地医院B超检测出胚芽长度达到了10mm才满足条件。
香港验血一家是女一家是男
2、确保宝妈没有经历过重大输血和器官移植等重大型手术,因为这会给检测结果带来很大的影响。
3、最后要保证宝妈12个月内没有经历过流产和分娩过男婴。
从得知自己怀孕的那一刻,相信很多孕妈一定是心里非常开心的,然而每个家庭情况是不一样的,一家欢喜一家愁,还有很多二胎,三胎孕妈妈想要儿女双全,二胎来了,欢喜的同时或许参杂着一丝忧愁,烦恼二胎是来了个男孩还是女孩。
为了能早点知道肚子里的孩子是男孩还是女孩,很多孕妈想通过香港测男女检测出来,那么很多孕妈就会有这样的疑问:我怀孕去验血就是想早点知道,为什么要我一定要等到七周,胚芽长度有10毫米或以上呢?
对香港测男女检测有所了解的孕妈就会知道,验血是需要满足一定的条件才是可以验男女的,这项检测之所以需要满7周才能检查,是因为伴随胎儿不断长大,DNA浓度还会越来越高,并在受孕后7周达到高峰。因此能准确通过DNA技术来判断胎儿性别,准确率可以达到99.9%。
香港验血定男女要抽多少血
以下为香港测男女要求
1、香港测男女需要孕妈妈怀孕7周以上,B超单胚芽长度达到10MM;
2、没有输血、器官移植等重大手术;
3、一年内没有生育过男孩;
4、一年内没有流产过男胎;(如是女孩则无关系);
很多没有验过的宝妈都可能道听途说过或多或少的知道点香港验血的事情,却不知道到底香港验血鉴定准不准确,会不会是,是什么原理检测出来的,都抱着怀疑的态度。在这里为大家分享宝妈们香港验血鉴定男女性别的真实经历和攻略。希望大家看完文章后都有所了解跟帮助!
香港验血要几周才能知道男女?
1、怀孕满7周 ,B超承认胚芽有10MM.有胎心搏动.
2、一年内没有生过男孩.
3、一年内没有进行过输血、严重手术、器官移植
4、血型为常见的群众血型,A型、B型、AB型、0型
5、半年内没有流产过男胎
6、这些都满足就能够检测
香港验血的流程
对于来到香港验血的大家一定要做好充足的准备,首先一定要找到一家靠谱的香港验血机构,大多数会通过中介查找,但是一定要找可信度高的中介伙伴,千万不能被坑了。之后就是要进行预约,最好是提前一两天就要预约好就诊时间,等到预约时间后到达验血机构出示自己的资料其中包括一张B超单,这是最重要的。
一切准备就绪后就可以开始对孕妇进行抽血了,全程做检查的时间不超过半小时,并且化验报告最快会在当天就出来,当然这是加急的情况下,但是检查结果一般不会超过一周。
以上就是大多数人在对于香港DNA抽血检测所会产生的疑问,香港验血总体来说比内地做的那些检查不论是在安全上还是准确率上都是更高一层的,选择这项检查项目不需要有太多担心。
每个孕妈怀孕都不容易,当准妈妈怀孕的时候,生男生女就成了家庭里最重要的一件事情,当准妈妈在怀孕期间,家人会去医院做B超检查,想要知道胎儿的性别。
相信大家都知道在国内医院做B超查,无论你用什么手段,医生都不会告诉你是男是女,因为国内是违法的,如果在这时候有种方法可以检测,你会怎么做?
香港DNA预约中心今天就给大家介绍一项科学医疗技术:香港验血测宝宝男女。在香港做验血查胎儿男女性别是合法的,而且准确率还特别的高。
说到这里就会有人问:香港验血测宝宝男女性别是什么?我们都知道,人的性别是由染色体决定的,在科学性方面女性别的染色体为XX,男性的染色体为XY。
根据科学研究人员发现,一种SRY基因只会存在与Y染色体上,一旦检测到它的存在,便意味着胎儿是男孩。利用这一信息,通过抽取孕妇手臂上的静脉血液中胎儿的,在有SRY基因来判断胎儿的性别。
准妈妈知道怀孕后,就会有一种很焦急的心想要知道宝宝性别,很多家庭都会出现这种正常情况,毕竟人人都有好求心,也有想要知道在宝宝出生之前提前准备好东西。
怀孕多久能去香港验血测宝宝男女,宝妈亲身经历告诉你!
那么去香港验血测宝宝男女性别需要准备什么吗?香港验血测宝宝男女性别最快几周做检查?
香港验血测男女性别需要准备什么呢?
一、首先你要去医院做B超检查,确认宝宝胎龄达到6周或以上、胚芽长度达到3mm或以上;
二、提前1~2天预约,因为香港医疗机构采用是是预约制的;
三、来香港检查之前要准备好港澳通行证,因为不管你是购物还是旅游,都必须有通行证才能过境;
香港验血测男女性别最快几周做检查?
一、香港验血测男女性别最快6周或者以上,胚芽长度达到3mm或者以上。
二、孕妇来香港前要确认半年内没有流产过男孩或生男孩,半年内没有做过重大手术器官移植或输血。
验血香港7周男孩单子
三、香港验血测宝宝男女只抽取孕妇手臂血液来进行检测,属于安全、无创检测,对孕妇和胎儿都没有任何伤害。
关于“香港验血测宝宝男女最快几周做检查”,孕妈们都有所了解了吧
怀胎十月中,准爸准妈们总是对腹中是男是女十分好奇,所以,香港验血是在孕妈群体里十分热门的话题。
现在香港验血分为邮寄验血,和亲自赴港验血这两种情况,那么哪种情况好呢,随小编来看看。
邮寄验血:就是孕妈在内地抽血,然后把血样寄到香港去,邮寄验血确实是挺方便的,只要找正规的检测机构检测是不会出现任何问题的
孕妇在内地抽血,能保证内地抽血的机构正规吗?抽血的机构符合医疗标准吗?抽血了对血液的保存能达到相关要求吗?
为什么香港验血都是女孩多
在内地操作验血是很简单的,具体的事宜可以咨询小编。
孕妇在内地抽了血,送到香港去,准确率都是一样的,样本会送到宝妈指定的化验所检测,结果都是可以通过官方网站和电话核实真伪的
所以,无论是邮寄验血也好,亲自去香港验血也好,准确率都是一样的,前提是必须要到正规的机构预约才可以,而且香港对于验血这块有足够的法律规范,可以说是安全又放心。
而且现在正逢过年,孕妈来香港还有很多好处!
1、到香港旅行玩耍,看看香港风土人情,换换心情
毕竟,怀孕是件很烦人的事情~早孕反应,家庭的期待,激素的变化,简直能把人折磨疯!所以呢,孕妈完全可以趁着孕早期,来香港散散心,到处走一走,看一看,换个心情。
毕竟,等到孕晚期肚子大了,哪里也去不了,想想就心累。
香港每逢过年,很多玩的地方都有优惠,孕妈过来的时候,只需要提前预约好酒店,就能开开心心的玩耍放轻松了。
2、过年香港许多商场打折,也可以到香港购买年货
年货这种事情,一到过年,总是压在女性头上的一大负担。可是,这些年货又不光是为了女性自己,却都要女性自己来操劳,想想就累。
可是,如果来香港购买年货,就正好有理由可以把老公叫来,你买年货他提东西,是吧。毕竟,就是他播的种才让你十月怀胎这么辛苦的!
而且,香港的关税收的比内地低,再加上过年优惠打折,来香港买年货也比内地便宜。
3.购买一些母婴产品及母婴奶粉
怀孕了,宝宝的衣物、奶粉、尿布,母婴用品是不是该考虑考虑了?而且自己怀孕期间的营养,孕妇奶粉是不是也该提上日程了?
可是,内地的母婴产品、奶粉这些东西不是说不好,只是,我们总想给宝宝最好的。
在内地呢,食品什么的标准低,准入门槛较低,不像香港、台湾等地执行欧盟、美加等国的标准高,准入门槛较高,自然让人放心些。
正是由于香港对进港的食品一直都非常严谨,所以才遭受内地的疯抢,这也是为什么香港政府下限奶令的原因。
所以呢,这就是比起邮寄验血,孕妈更愿意亲自来香港验血的原因,毕竟,这是一件一举多得的事情。
[香港验血测男女能吃早餐吗][我去香港验血查性别鉴定真实经历][香港验血男孩有几个小时][有香港验血是男孩生了女孩吗][有香港化验血男转女的吗][孕11周还能香港验血测男女吗]